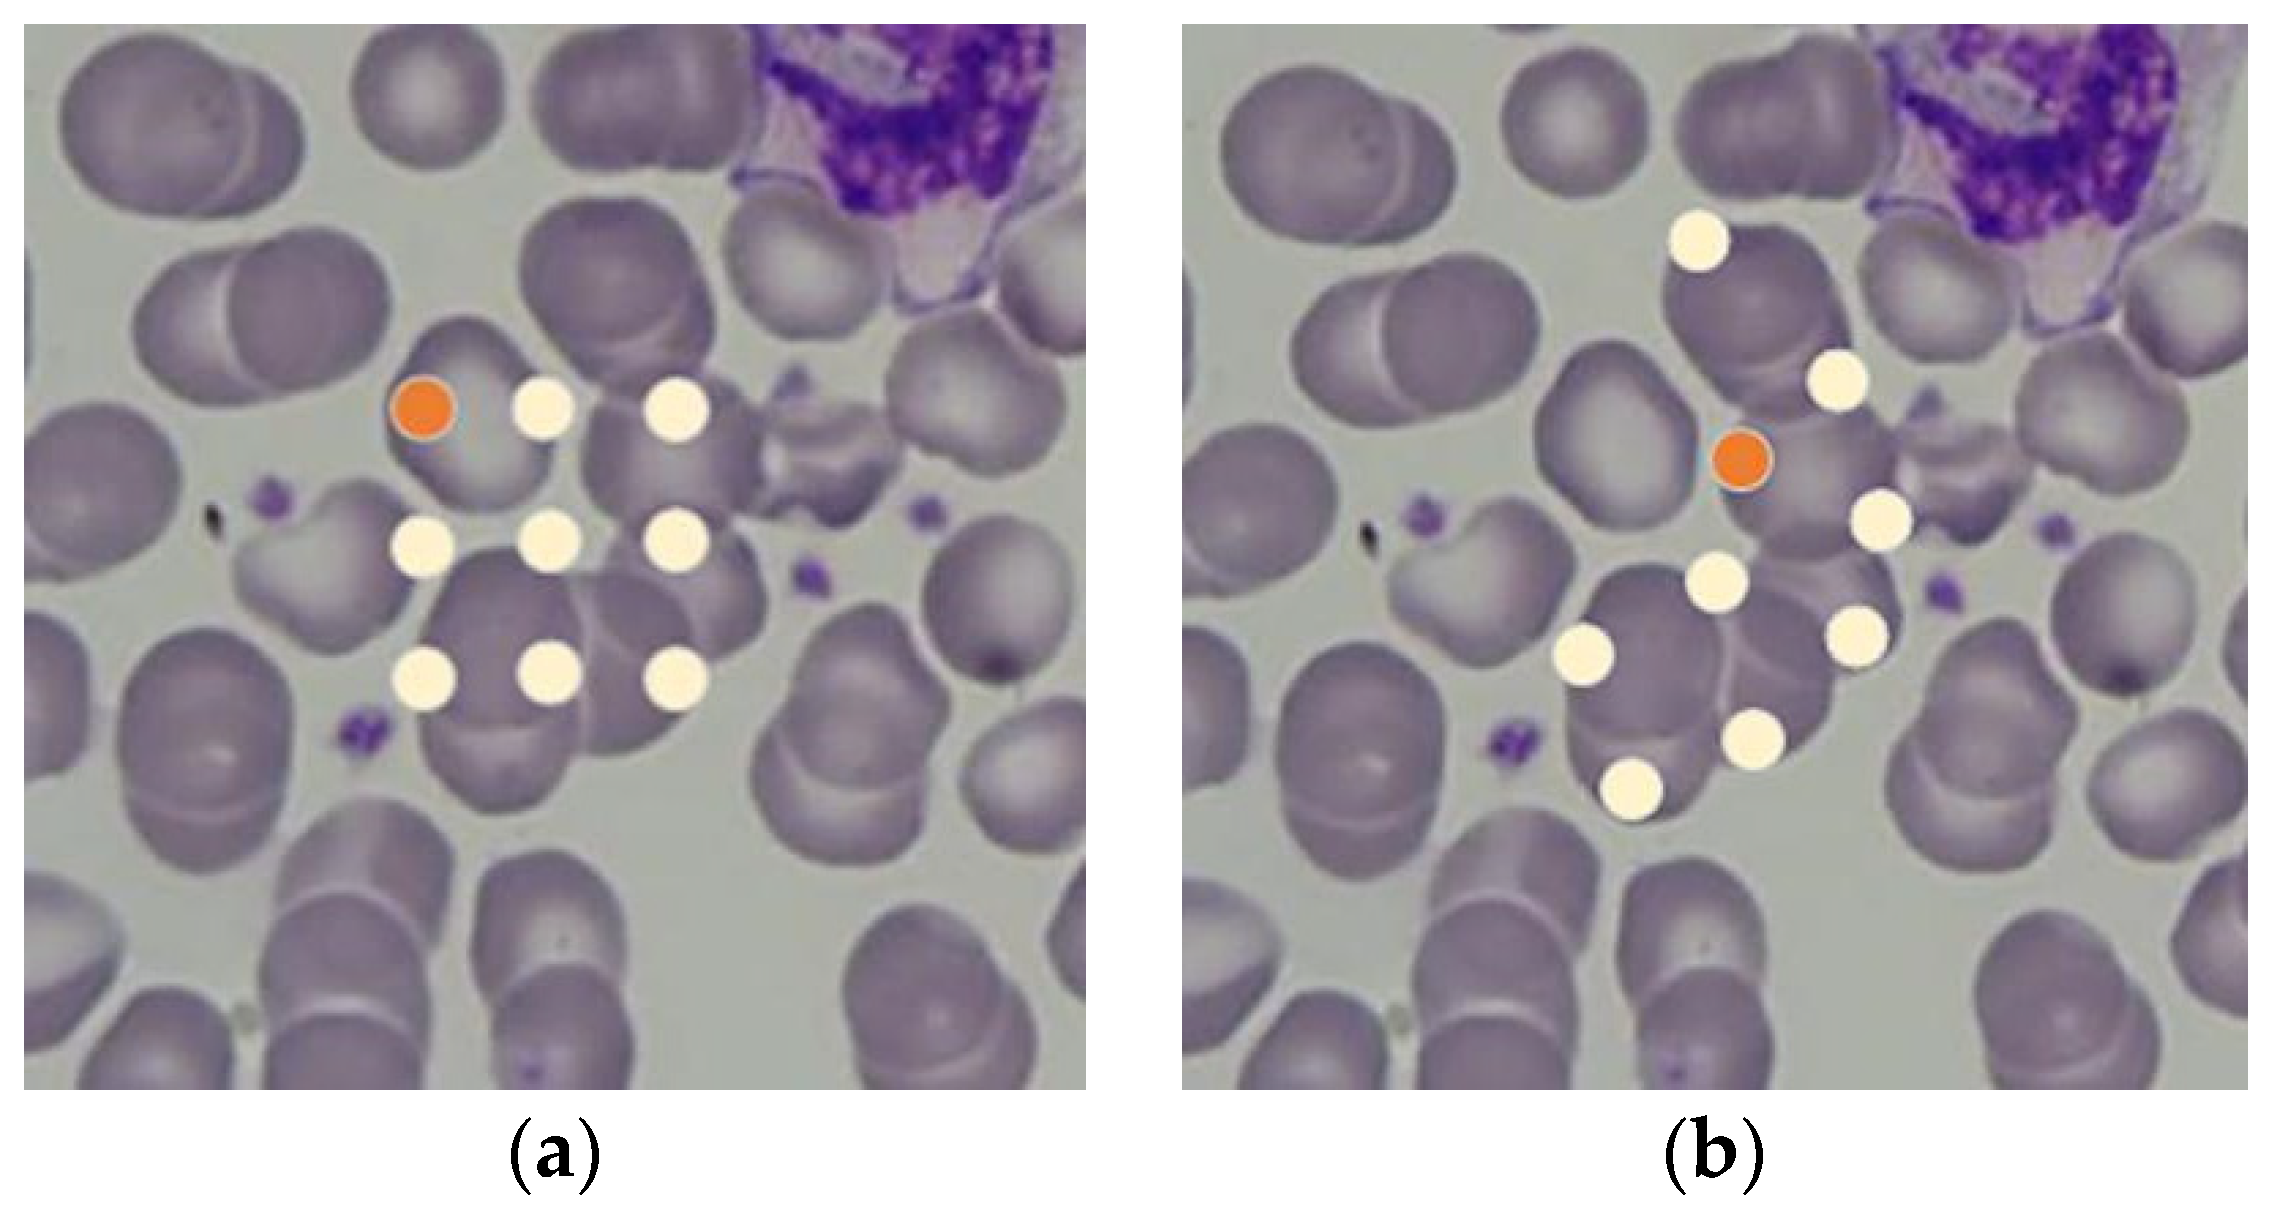
Applsci 13 12412 g002

Automatic Recognition of Blood Cell Images with Dense Distributions Based on a Faster Region-Based Convolutional Neural Network
Abstract
:1. Introduction
2. Methods
2.1. Network Structure
- The labeling results inevitably contain some non-target information due to the dense distributions of cells in the complex environment, which leads to an increased false detection rate.
- The squeezing of cells may happen, resulting in irregular morphology. This increases the difficulty of feature extraction.
- There are single red cells, agglomerated red cells, white blood cells or other impurities in an actual medical scene. These cause the problem of multi-scale recognition and reduce the range of receptive field.
2.2. BFP Module
2.3. DCN Module
2.4. EPSA Module
2.5. ROI Align Module
3. Experiments and Analyses
3.1. Dataset
3.2. Evaluation Indexes
3.3. Result Analyses
3.3.1. Results of Ablation Experiments
3.3.2. Results of Comparison Experiments
4. Conclusions
Author Contributions
Funding
Institutional Review Board Statement
Informed Consent Statement
Data Availability Statement
Conflicts of Interest
References
- Vala, M.H.J.; Baxi, A. A review on otsu image segmentation algorithm. Int. J. Adv. Res. Comput. Eng. Technol. 2013, 2, 387–389. [Google Scholar]
- Haris, K.; Efstratiadis, S.N.; Maglaveras, N.; Katsaggelos, A.K. Hybrid image segmentation using watersheds and fast region merging. IEEE Trans. Image Process. 1998, 7, 1684–1699. [Google Scholar] [CrossRef] [PubMed]
- Yi, F.; Moon, I.; Javidi, B. Cell morphology-based classification of red blood cells using holographic imaging informatics. Biomed. Opt. Express. 2016, 7, 2385–2399. [Google Scholar] [CrossRef] [PubMed]
- Gao, C.; Zhou, D.; Guo, Y. An iterative thresholding segmentation model using a modified pulse coupled neural network. Neural Process. Lett. 2014, 39, 81–95. [Google Scholar] [CrossRef]
- Sundara, S.M.; Aarthi, R. Segmentation and evaluation of white blood cells using segmentation algorithms. In Proceedings of the 2019 3rd International Conference on Trends in Electronics and Informatics (ICOEI), Tirunelveli, India, 23–25 April 2019; pp. 1143–1146. [Google Scholar]
- Zhang, Y.C.; Xu, N.; Chen, H.M.; Lam, W.H.; Zhang, X.; Qiu, T. A robust and high-performance white blood cell segmentation algorithm. In Proceedings of the IEEE 2020 5th International Conference on Computer and Communication Systems (ICCCS), Shanghai, China, 15–18 May 2020; pp. 347–351. [Google Scholar]
- Harris, C.G.; Stephens, M.J. A combined corner and edge detector. In Proceedings of the 4th Alvey Vision Conference, Manchester, UK, 31 August–2 September 1988; pp. 147–151. [Google Scholar]
- Tang, Z.J.; Huang, L.Y.; Zhang, X.Q.; Lao, H. Robust image hashing based on color vector angle and Canny operator. Int. J. Electron. Commun. 2016, 70, 833–841. [Google Scholar] [CrossRef]
- Zhang, Y.; Han, X.; Zhang, H.; Zhao, L.M. Edge detection algorithm of image fusion based on improved sobel operator. In Proceedings of the 2017 IEEE 3rd Information Technology and Mechatronics Engineering Conference (ITOEC 2017), Chongqing, China, 3–5 October 2017; pp. 457–461. [Google Scholar]
- Ma, Y.L.; Ma, H.Y.; Chu, P.C. Demonstration of quantum image edge extration enhancement through improved sobel operator. IEEE Access 2020, 8, 210277–210285. [Google Scholar] [CrossRef]
- Tai, W.L.; Hu, R.M.; Hsiao, H.C.W.; Chen, R.M.; Tsai, J.J.P. Blood cell image classification based on hierarchical SVM. In Proceedings of the 2011 IEEE International Symposium on Multimedia, Dana Point, CA, USA, 5–7 December 2011; pp. 129–136. [Google Scholar]
- Rezatofighi, S.H.; Soltanian-Zadeh, H. Automatic recognition of five types of white blood cells in peripheral blood. Comput. Med. Imag. Grap. 2011, 35, 333–343. [Google Scholar] [CrossRef] [PubMed]
- Ren, S.; He, K.; Girshick, R.; Sun, J. Faster R-CNN: Towards real-time object detection with region proposal networks. IEEE Trans. Pattern Anal. Mach. Intell. 2016, 39, 1137–1149. [Google Scholar] [CrossRef] [PubMed]
- Redmon, J.; Divvala, S.; Girshick, R.; Farhadi, A. You only look once: Unified, real-time object detection. In Proceedings of the 2016 IEEE Conference on Computer Vision and Pattern Recognition, Las Begas, NV, USA, 27–30 June 2016; pp. 779–788. [Google Scholar]
- Liu, W.; Anguelov, D.; Erhan, D.; Szegedy, C.; Reed, S.; Fu, C.Y.; Berg, A.C. SSD: Single shot multibox detector. arXiv 2015, arXiv:1512.02325. [Google Scholar]
- Han, H.Z.; Wei, B.; Sui, D.; Li, S. A U-Net-based method for detection of cancer cells in pathological sections of breast cancer. J. Precis. Med. 2018, 33, 471–473. [Google Scholar]
- Banik, P.P.; Saha, R.; Kim, K.D. An automatic nucleus segmentation and CNN model based classification method of white blood cell. Expert Syst. Appl. 2020, 149, 113211. [Google Scholar] [CrossRef]
- Chen, L.; Xue, H.R.; Gao, X.J.; Zhang, X.L.; Bai, J. Milk somatic cells recognition based on dichotomy method and BP neural network. J. Inner Mong. Agric. Univ. (Nat. Sci. Ed.) 2020, 41, 69–74. [Google Scholar]
- Lavitt, F.; Rijlaarsdam, D.J.; van der Linden, D.; Weglarz-Tomczak, E.; Tomczak, J.M. Deep learning and transfer learning for automatic cell counting in microscope images of human cancer cell lines. Appl. Sci. 2021, 11, 4912. [Google Scholar] [CrossRef]
- Anand, K.; Meena, J.; Srinivas, B.; Animesh, M.; Girija, C.; Praveen, K.S.; Sanjib, M.; Timir, K.P.; Jyoti, M.; Ajat, H. Deep learning for real-time malaria parasite detection and counting using YOLO-mp. IEEE Access 2022, 10, 102157–102172. [Google Scholar]
- Pang, J.M.; Chen, K.; Shi, J.P.; Feng, H.J.; Ouyang, W.L.; Lin, D.H. Libra R-CNN: Towards balanced learning for object detection. In Proceedings of the 2019 IEEE/CVF Conference on Computer Vision and Pattern Recognition (CVPR), Long Beach, CA, USA, 15–20 June 2019; pp. 821–830. [Google Scholar]
- Dai, J.F.; Qi, H.Z.; Xiong, Y.W.; Li, Y.; Zhang, G.D.; Hu, H.; Wei, Y.C. Deformable convolutional networks. In Proceedings of the 2017 IEEE International Conference on Computer Vision (ICCV), Venice, Italy, 22–29 October 2017; pp. 764–773. [Google Scholar]
- Zhang, H.; Zu, K.; Lu, J.; Zou, Y.; Meng, D.Y. EPSANet: An efficient pyramid squeeze attention block on convolutional neural network. arXiv 2021, arXiv:2015.14447. [Google Scholar]
- Lin, T.Y.; Dollár, P.; Girshick, R.; He, K.M.; Hariharan, B.; Belongie, S. Feature pyramid networks for object detection. In Proceedings of the 2017 IEEE Conference on Computer Vision and Pattern Recognition, Honolulu, HI, USA, 21–26 July 2017; pp. 936–944. [Google Scholar]
- Wang, X.; Girshick, R.; Gupta, A.; He, K.M. Non-local neural networks. In Proceedings of the 2018 IEEE Conference on Computer Vision and Pattern Recognition, Salt Lake City, UT, USA, 18–23 June 2018; pp. 7794–7803. [Google Scholar]
- He, K.; Gkioxari, G.; Dollár, P.; Girshick, R. Mask R-CNN. IEEE Trans. Pattern Anal. Mach. Intell. 2020, 42, 386–397. [Google Scholar] [CrossRef] [PubMed]
- Yue, W.; Liu, S.; Li, Y. Eff-PCNet: An efficient pure CNN network for medical image classification. Appl. Sci. 2023, 13, 9226. [Google Scholar] [CrossRef]
- Tsung, Y.L.; Goyal, P.; Girshick, R.; He, K.; Dollar, P. Focal loss for dense object detection. IEEE Trans. Pattern Anal. Mach. Intell. 2020, 42, 318–327. [Google Scholar]

| Model | BFP | DCN | EPSA | ROI Align | Type | Recall | Precision | mAP | F1 |
|---|---|---|---|---|---|---|---|---|---|
| Original model | × | × | × | × | SRBC | 0.686 | 0.761 | 0.731 | 0.722 |
| ARBC | 0.587 | 0.505 | 0.545 | 0.543 | |||||
| MIX | 0.664 | 0.754 | 0.719 | 0.706 | |||||
| Model 1 | × | × | √ | √ | SRBC | 0.772 | 0.811 | 0.793 | 0.791 |
| ARBC | 0.666 | 0.752 | 0.710 | 0.706 | |||||
| MIX | 0.736 | 0.791 | 0.769 | 0.763 | |||||
| Model 2 | √ | × | √ | √ | SRBC | 0.886 | 0.923 | 0.905 | 0.904 |
| ARBC | 0.782 | 0.865 | 0.823 | 0.821 | |||||
| MIX | 0.838 | 0.897 | 0.874 | 0.866 | |||||
| BDE_RCNN | √ | √ | √ | √ | SRBC | 0.895 | 0.942 | 0.919 | 0.918 |
| ARBC | 0.796 | 0.887 | 0.842 | 0.839 | |||||
| MIX | 0.868 | 0.921 | 0.895 | 0.894 |
| Model | Recall | Precision | mAP | F1 |
|---|---|---|---|---|
| SSD | 0.586 | 0.659 | 0.611 | 0.620 |
| YOLOv5 | 0.717 | 0.804 | 0.764 | 0.758 |
| RetinaNet | 0.808 | 0.856 | 0.837 | 0.831 |
| BDE_RCNN | 0.868 | 0.921 | 0.895 | 0.893 |
Disclaimer/Publisher’s Note: The statements, opinions and data contained in all publications are solely those of the individual author(s) and contributor(s) and not of MDPI and/or the editor(s). MDPI and/or the editor(s) disclaim responsibility for any injury to people or property resulting from any ideas, methods, instructions or products referred to in the content. |
© 2023 by the authors. Licensee MDPI, Basel, Switzerland. This article is an open access article distributed under the terms and conditions of the Creative Commons Attribution (CC BY) license (https://creativecommons.org/licenses/by/4.0/).
Share and Cite
Liu, Y.; Liu, Y.; Chen, M.; Xue, H.; Wu, X.; Shui, L.; Xing, J.; Wang, X.; Li, H.; Jiao, M. Automatic Recognition of Blood Cell Images with Dense Distributions Based on a Faster Region-Based Convolutional Neural Network. Appl. Sci. 2023, 13, 12412. https://doi.org/10.3390/app132212412
Liu Y, Liu Y, Chen M, Xue H, Wu X, Shui L, Xing J, Wang X, Li H, Jiao M. Automatic Recognition of Blood Cell Images with Dense Distributions Based on a Faster Region-Based Convolutional Neural Network. Applied Sciences. 2023; 13(22):12412. https://doi.org/10.3390/app132212412
Chicago/Turabian StyleLiu, Yun, Yumeng Liu, Menglu Chen, Haoxing Xue, Xiaoqiang Wu, Linqi Shui, Junhong Xing, Xian Wang, Hequn Li, and Mingxing Jiao. 2023. "Automatic Recognition of Blood Cell Images with Dense Distributions Based on a Faster Region-Based Convolutional Neural Network" Applied Sciences 13, no. 22: 12412. https://doi.org/10.3390/app132212412
APA StyleLiu, Y., Liu, Y., Chen, M., Xue, H., Wu, X., Shui, L., Xing, J., Wang, X., Li, H., & Jiao, M. (2023). Automatic Recognition of Blood Cell Images with Dense Distributions Based on a Faster Region-Based Convolutional Neural Network. Applied Sciences, 13(22), 12412. https://doi.org/10.3390/app132212412

